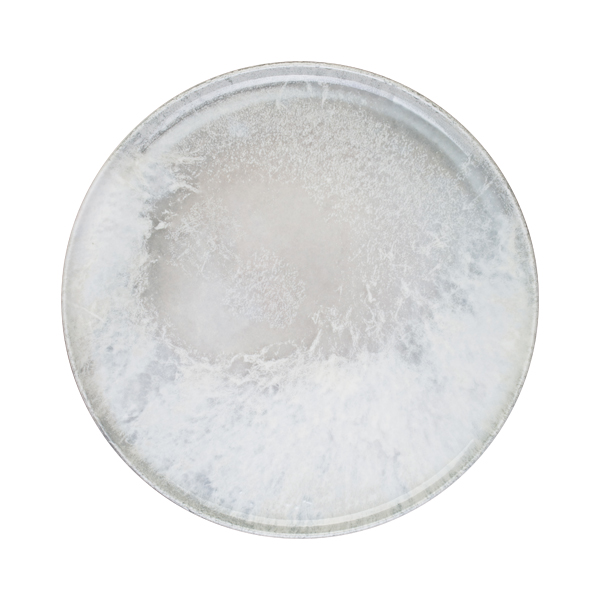

Surf Mesa Pizza Plate 31 cm
Product code: 20265-171731
SHARE:
The Surf Mesa Pizza Plate by Bonna combines elegance and durability, making it ideal for restaurants and cafes. Crafted from high-quality porcelain, this 31 cm plate features lifetime edge cracking resistance, ensuring long-lasting use. Perfect for serving delicious pizzas, it enhances the dining experience with its stylish design.




